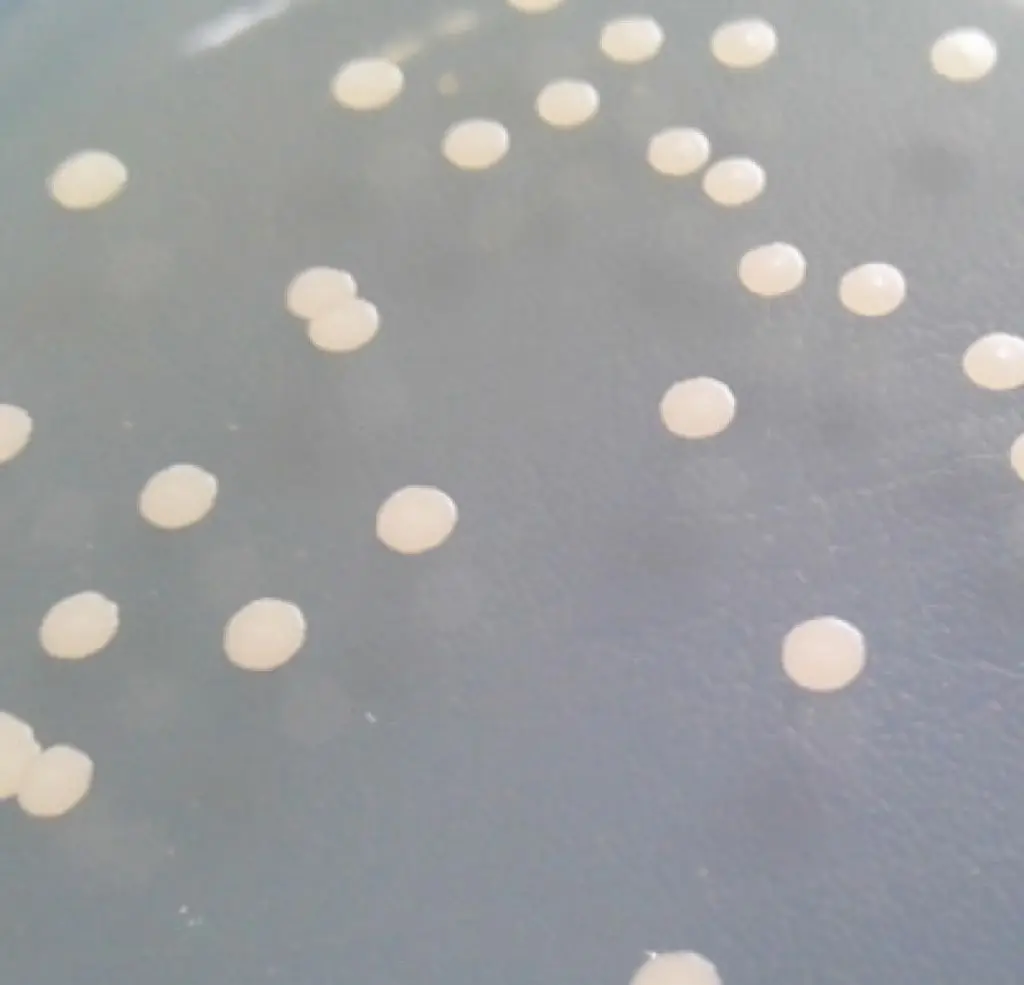
Bacillus megaterium

Bacillus megaterium
- Category: Microecology >>>
- Supplier: Hebei Green Element Biotechnology Co. Ltd.
Share on (1600435258759):
Product Overview
Description
Product Description
Specification
1 | Release available phosphorus to improve fertilizer efficiency |
2 | Promote plant growth Improve stress resistance |
3 | Improve soil and reduce pesticide residues |
4 | Improve the quality of agricultural products |
Instructions
Packing & Delivery


To better ensure the safety of your goods, professional, environmentally friendly, convenient and efficient packaging services will be provided.
Company Profile
Semi-Automatic PET Bottle Blowing Machine Bottle Making Machine Bottle Moulding Machine
PET Bottle Making Machine is suitable for producing PET plastic containers and bottles in all shapes.
PET Bottle Making Machine is suitable for producing PET plastic containers and bottles in all shapes.
FAQ
Semi-Automatic PET Bottle Blowing Machine Bottle Making Machine Bottle Moulding Machine
PET Bottle Making Machine is suitable for producing PET plastic containers and bottles in all shapes.
PET Bottle Making Machine is suitable for producing PET plastic containers and bottles in all shapes.
We Recommend
New Arrivals
New products from manufacturers at wholesale prices